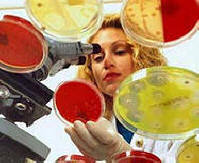
Az antibiotikumok lelassítják az öregedési folyamatot

fénykép nyílt forrásokból
fénykép nyílt forrásokból
A Lausanne Szövetségi Politechnikai Iskola tudósai felfedezett egy olyan géncsoportot, amely jelentősen befolyásolja a várható élettartam, és ezt a folyamatot kontrollálhatjuk rendelkezésre álló gyógyszerek, különösen antibiotikumok használata. svájci a tudósok fedezték fel először a mitokondriumokban működő mechanizmust és jelentősen lelassítja az öregedési folyamatot, legalábbis 2006 – ban laboratóriumokban és mintaorganizmusokon – férgek, fonálférgek és egerek. Kiderült, hogy az antibiotikumok bevezetése a fiatalok körében jelentősen befolyásolhatja meghosszabbítja az állatok és esetleg az emberek életét.
Miért ugyanannak a fajnak a homogén populációjában? az emberek háromszor hosszabb ideig élnek, mint mások? Ez a kérdés felmerült A tudósok évszázadokon belüli ásványa A svájci tudósok hisznek hogy megtalálta a választ erre. Felfedik egy mechanizmust, amelynek megsértése a antibiotikumok használata növeli a fonálféreg élettartamát 1,6-szor. Nyilvánvaló, hogy ugyanaz a mechanizmus növeli az egereket (általában 365-900 napot élve) további 250 nap az élet.
A mechanizmus működik a mitokondriumokban, az organellákban, amelyek átalakítani a tápanyagokat fehérjékké és ATP-ként mint energiaforrás az izmok számára. A tudósok elemezték a genomot különböző élettartamú egerekből három csoportot találtak a második kromoszómán található gének, ami még mindig nem célpontnak tekintették a fontos öregedési tényezők megtalálását. A mérések azonban megmutatták: e három expressziójának 50% -os csökkenése gének, és ennélfogva az általuk kódolt fehérjemennyiség, 250 “extra” napot ad az egereknek.
Ezután a tudósok fonálférgekkel tesztelték felfedezésüket: redukció ugyanazon fehérjék előállítása szintén meghosszabbította az élettartamot: 60% -kal (a hagyományos proteinekből) 19 – több mint 30 nap). Általában a tanulmány megállapította, hogy a mitokondriális riboszómális proteinek (MRP) jelenléte vissza a várható élettartammal arányosan. Csökkentse ezek számát a fehérjék például rendelkezésre álló gyógyszereket használhatnak, antibiotikumok. Sajnos ilyen módon meghosszabbíthatja életét. csak fiatal személyeknél: a felnőtteknél hasonló kezelés nem cselekszik.
A svájci tudósok felfedezése ragyogó kilátásokat ígér élet meghosszabbítási terv. Az új mechanizmus egyszerű, és nem csak növekszik élettartama, de hosszú ideig lehetővé teszi az egészség fenntartását. Tehát a kezelt fonálférgek be vannak kiváló forma, sokkal hosszabb, mint a testvéreik, és birtokolt megnövekedett állóképesség és izomerő.
A tudósok úgy vélik, hogy a felfedezett mechanizmus működik más emlősök, beleértve az embereket is. Igaz, hogy hozzon létre megfelelő, egészséges életet meghosszabbító terápiára van szükség nagyon összetett és hosszú kutatás. Először a terápia a fiatalok szigorúan meghatározott fejlődési időszakában kell elvégezni szervezetét, és az emberek számára ezt az időszakot még nem határozták meg, és másodszor: hogy megkapja az emberi terápia eredményeit Gyűjtsük össze az egész életen át tartó statisztikákat a kísérleti alanyokból. De valószínűleg hajlandó részt venni egy ilyen kísérletben elég.
Az élet ideje






